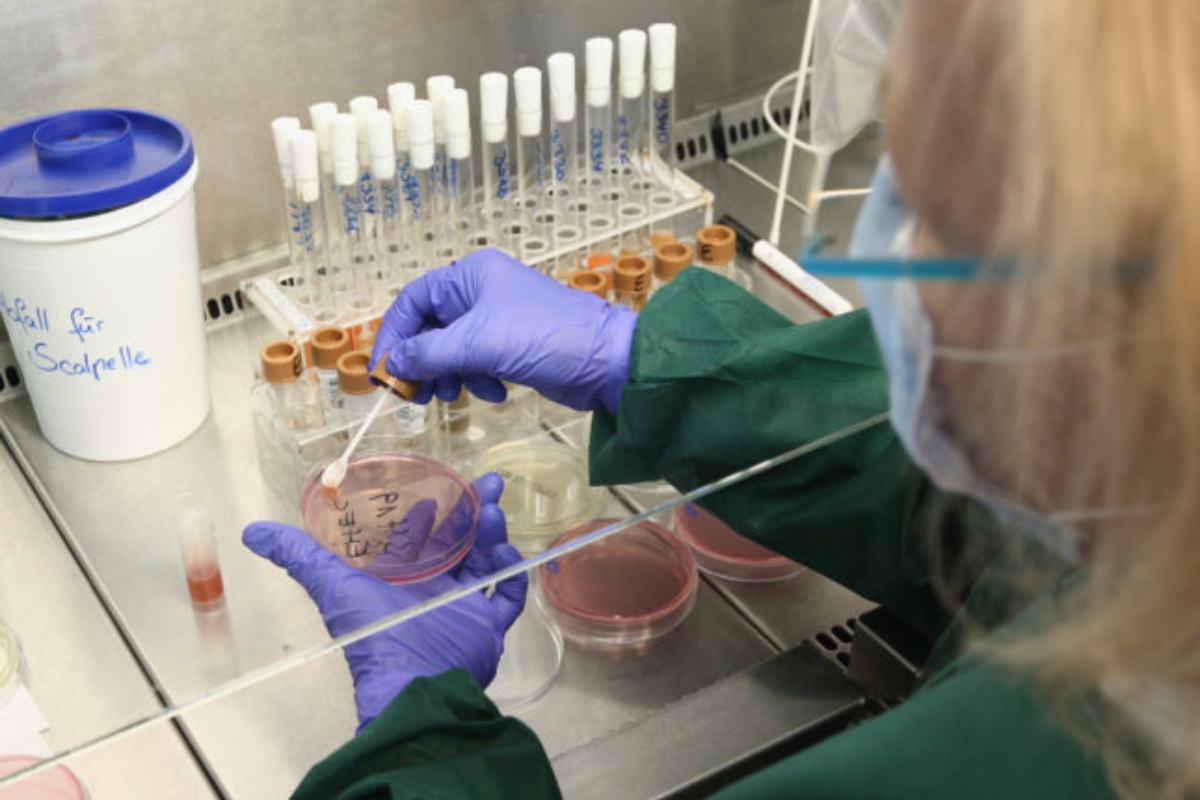
Polio

PMD issues weather alerts for Karachi and Khyber Pakhtunkhwa
Karachi: The Pakistan Meteorological Department (PMD) has issued a weather advisory for Karachi, noting a significant increase in air pollution today. The particulate matter concentration in the air has reached 162 micrograms per cubic meter, indicating hazardous air quality. The city is expected to remain hot throughout the day, with temperatures potentially reaching 36°C. Humidity levels are currently at 87%,